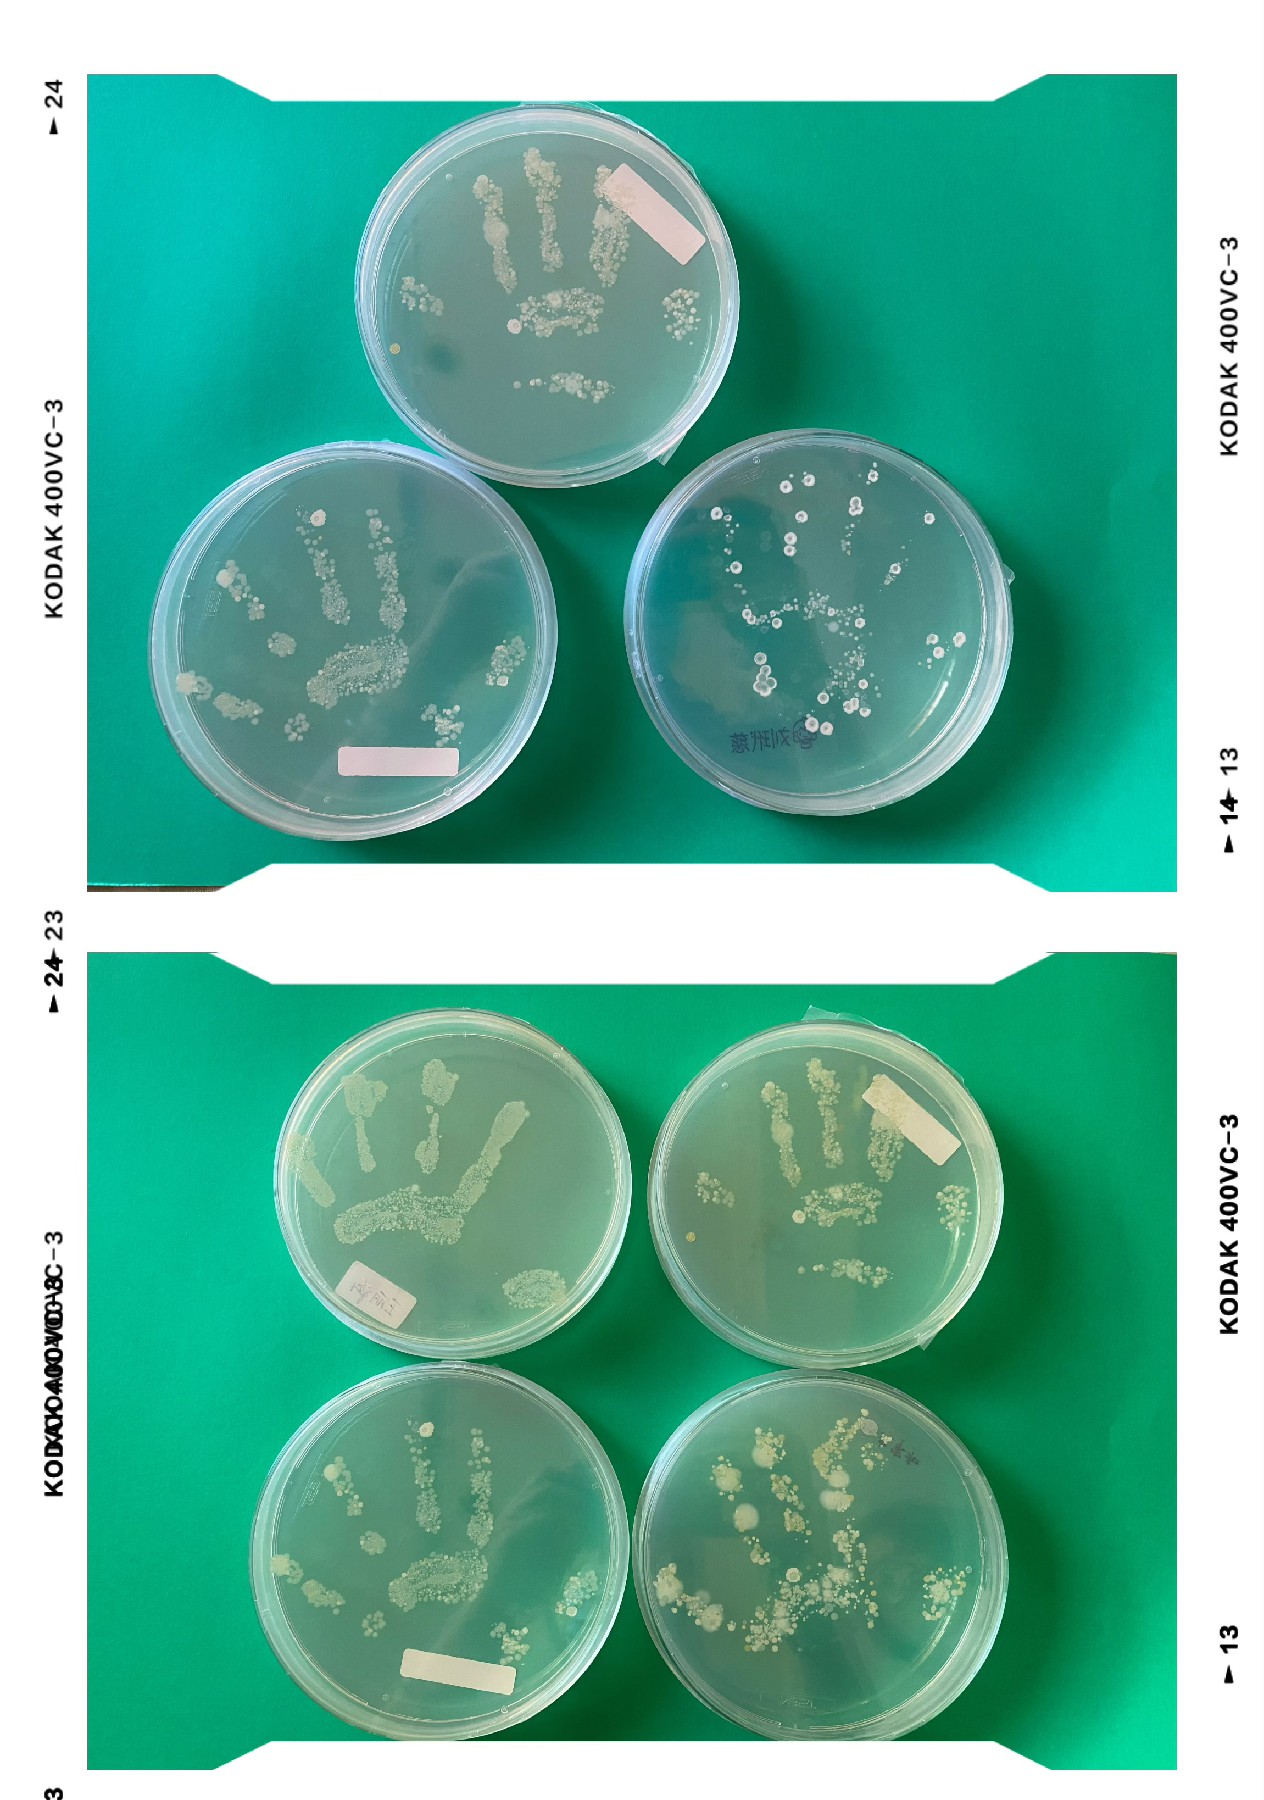

秋季虽至,气温下降,细菌却并没有停止滋生。为了让小朋友们“看到”生活中肉眼看不到的细菌等微生物,我们特别邀请到朵朵一班王可伊小朋友的妈妈——东北师范大学生命科学学院张瑜老师作为家长助教带领课题组的学生们来到幼儿园开展了别开生面的幼儿生物知识科普活动。

此次活动以“无处不在的细菌”为主题,伊伊妈妈带领学生认真准备、精心组织,用通俗易懂的语言和活泼生动的演示,向孩子们讲解了关于细菌的相关知识,在他们的心里种下了一颗养成良好卫生习惯的种子,同时也激发孩子们对于生物学知识的兴趣。

伊伊妈妈通过贴近生活的知识讲解,让每位小朋友形象地认识到细菌的存在,她还设置相关趣味性极强的生物学实验,让每位小朋友直观地看到“何为细菌”。
伊伊妈妈还以现实生活情景举例为小朋友们讲解细菌无处不在:在小朋友每次玩完游戏的双手上、在长期摆在家中闲置的玩具上、在小朋友打出的喷嚏中、在小朋友的牙齿上、在掉落的饭菜上、在腐烂的水果上……日常生活中随处可见的情景形象生动地帮助小朋友们认识了细菌的存在。


同时,为了更加直观地让小朋友们认识到细菌的存在,伊伊妈妈通过实验,让每一个小朋友将自己的手掌印在准备好的琼脂糖固体培养基上(高温高压灭菌,无毒无害)。

最后细菌在培养皿中长成手掌的形状,孩子们更加清晰的观察到细菌的存在。在互动环节中,孩子们积极参与、主动思考、热情高涨,展现出旺盛的求知欲望,现场气氛非常活跃。








朵朵一班小朋友和家长助教老师一起提醒大朋友、小朋友们:要从幼儿阶段,养成良好的生活习惯,抵御细菌病毒侵袭,追求健康生活。同时要增强身体健康意识,掌握基本个人卫生知识。
